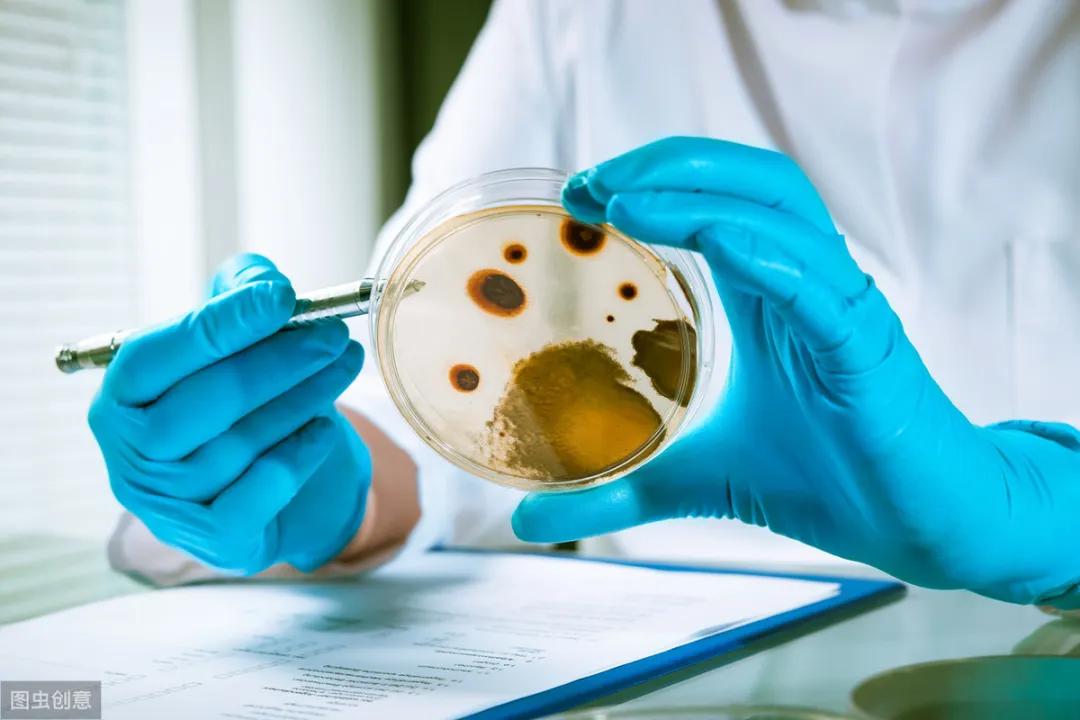
冰箱里隐藏的杀手大家不得不防,冰箱散发什么有害物质

冰箱隐藏个"致癌杀手",还发出臭味!开水烫不死,放个"蛋"才搞定
夏季有些人腹痛、呕吐、发烧等疾病多发,很大的原因就是家庭冰箱的清洁、除湿、消毒工作没做好。
其实90%的人都不知道,冰箱里藏着各种各样的细菌群,
放置其中的食物很容易因这些
“不怕低温”的细菌污染散发异味。

央视财经频道曾经报道过,冰箱不是“保险箱”,多种细菌易滋生!

回想一下,家里的冰箱,你多久清理一次呢?
我想很多人跟我一样,都是等到忽然被冰箱里的臭味熏到或者是拉抽屉很费劲了,才会意识到家里的冰箱该要好好擦洗了。
早在2010年,全球卫生理事协会曾做过一项《家庭卫生报告》调查,显示家里常用的冰箱是排名第二最脏的地方,仅次于浴室密封条——甚至“污”过马桶40倍!
“细菌密密麻麻,全堆积在了食物上。
大家肉眼看不见,一口一口全吃进肚子里了,
认真一想,这简直太可怕了。”

而不做消毒处理,仅仅靠抹布擦一擦基本是没用的。
西瓜吃出韭菜味?面膜用出泡菜味?
大倒胃口不说,家里老人小孩因为吃到“冰箱杀手”而拉肚子发烧生病,跑医院花钱受罪才是最最焦心的了!
那有没有什么办法可以很方便的给冰箱除味抑菌?
当然是有的,
今天小编遍寻全网的
这款长白山小黄鸡硅藻除味蛋
正好能够解决这个困扰。

推荐理由:
1、长白山除味蛋材质天然安全,可以有效吸附异味、去除湿气。
2、硅藻土内部独特的孔隙结构和速干特性,使得:一个蛋的除臭能力,等于500包活性炭。
3、不含有重金属和化学物质,更能抗菌防霉、净化空气,哪里需要放哪里。

真的这么好用吗?我们来看看大家试用的效果
很方便好用,效果明显,第二天气味减弱,第三天就没有异味了。

长的像鸡蛋,效果好,硅藻土材质天然。


朋友家冰箱都没有异味了,
买了十个,四个放冰箱,过一两天冰箱里就没什么味道了。

堪称除臭界的传奇——硅藻土
硅藻土结构非常稳定,严格无毒,不含金属等化学物质,不易发生化学反应,其独特的超微细孔结构,比木炭还要多出5000-6000倍,有着很强的吸附力。
一个蛋的除臭能力,等于500包活性炭
现在连红茶加工,啤酒及葡萄酒的过滤上也常被用到。

我们冰箱里呢都是入口的食物,安全天然才是第一条!
不像市面上很多冰箱除味产品
有的仅仅是用香味掩盖异味实在是没用;
有的要释放气体发生化学反应;
而那些需要喷洒在食物表面的*剂喷**更是让我们化学不好的人顾!虑!重!重!

这个长白山强效除味蛋就不同了,直接把大自然的天然宝藏搬运进我们冰箱,迅速除味吸湿,还能有效抑制细菌、净化空气,简直是太完美了!

央视【走进科学】栏目曾经做过实验,研究者往两个分别装有硅藻土样板和普通涂料样板的密闭容器中放入同量具有呛人气味的*水氨**,

40分钟后,左边硅藻土样板中的抽样气体浓度已下降为有20mg每立方米,而右边的普通样板还保持在200mg每立方米。
实验证明,硅藻土对有害气体的吸附能力是相当强的!
最好的硅藻土在中国长白山
众所周知,硅藻土应用于家居环境最开始兴起于日本。
日本二战后由于工业快速膨胀,致使污染严重,再加上其高湿环境,成为日本国民健康忧患。
90年代初,崇尚天然的日本发现了“会呼吸能脱臭、可调节室内湿度、还可简单净化空气”硅藻土,将细节用材渗透到整个民族血液中的日本人迅速将其应用于家居中,可以说户户装修装饰都能看到硅藻土的影子。
看日本电视台怎么介绍硅藻土的?
“用在家里非常好,因为是植物化石,
安全到可以吃”
但是仔细去查下资料就会发现,日本的硅藻土有着天然的缺陷。
日本硅藻土储量高,但优质土不多,他们的硅藻土产品往往需要掺杂一些其他材料,比如聚乐土、备长炭、川砂、沸石等材料,以此弥补劣质硅藻土的不足,但是这样的硅藻土后期使用存在隐患。

再加上日本福岛曾发生核泄漏,硅藻土主产区基本都有可能因为硅藻土的吸附性携带放射性物质。
世界上三处优质的硅藻土矿主要集中在中国和美国,而中国的长白山地区独占两处。
我们的硅藻土除味蛋就来自于长白山最优质硅藻土产区,全部由手工精制而成,空隙率达90%,是普通活性炭的5000-6000倍!
经检测,长白山优质硅藻土脱臭除味,调节湿度,吸附有害气体能力更强。
小身材,能力超强
当你拿到长白山硅藻土除味蛋的时候,可以看到它就是硅藻土最天然的颜色,完全没有那种为了凹造型而加色素染成五颜六色的废动作。

它的形状呢跟我们家买的土鸡蛋差不多,大一些,圆嘟嘟沉甸甸的很可爱,非常适合放在冰箱的各个角落,一点儿也不占地方,接触面积又大,吸味效果特别好。
天然的长白山硅藻土不含有重金属等不安全化学物质,反而含有一些对人体非常有益的矿物质。
一个蛋的除臭能力,等于500包活性炭,绝对是堪称除臭届的传奇!

长白山小黄鸡硅藻除味蛋,顺利通过广微测严格的检验认证,完全符合安全标准,你绝对可放心使用哦!

衣柜防霉、鞋柜除味、卫生间除湿,车内净化,全都需要这颗蛋。衣柜里防霉、浴室里除湿、鞋柜里去味,抽屉里除湿除味吸甲醛、都可以放上一颗长白山除味蛋。

这款长白山小黄鸡冰箱除臭蛋,价格不贵,原价39块钱每盒,现在#618# 活动价2盒才39.9块。一份快餐、一包烟的钱,就可以搞定一年的异味和家人健康保障。
快点击下面进入购买↓
【特惠2盒39.9】冰箱除味剂100g 快速祛异味
¥39.9
购买